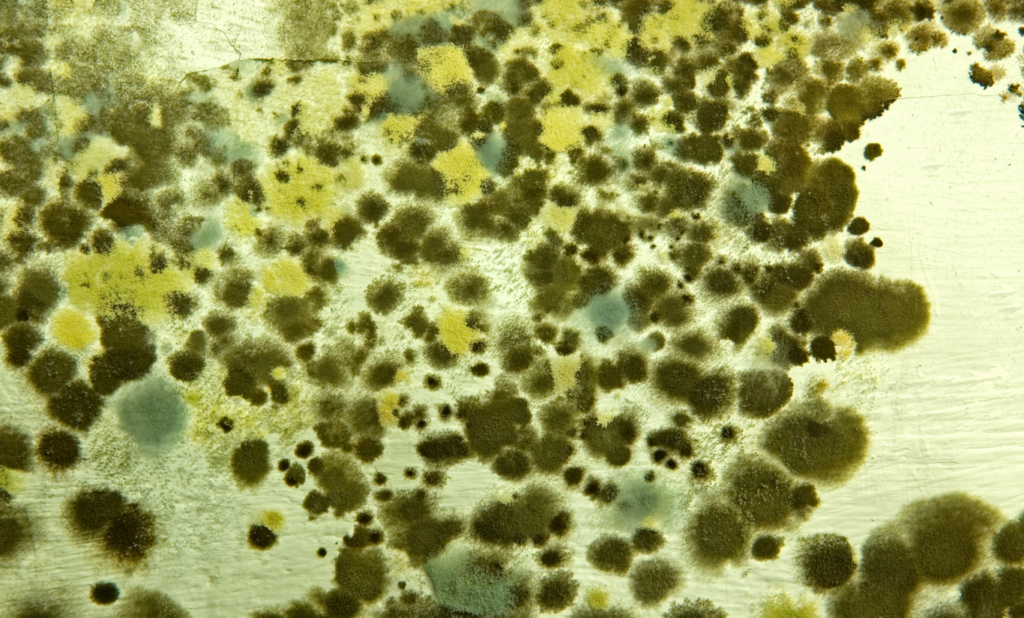
metabolic health. mold and mycotoxins

When people think about their health, they often focus on symptoms like fatigue, joint pain, brain fog, or stubborn weight gain. What’s frequently overlooked is why these symptoms develop in the first place. At ViveWell Health, we look deeper. One of the most effective ways to understand and improve metabolic health is by addressing what we call The 3 M’s: Mycotoxins, Metals, and Metabolism.
These three factors are some of the biggest stressors on the body today. When left unaddressed, they disrupt energy production, hormone balance, inflammation control, and the body’s ability to heal. By identifying and correcting these stressors, ViveWell Health helps patients restore metabolic health so they can live with more energy, less pain, and a renewed sense of wellbeing.
Mycotoxins and Mold: Hidden Stressors on Metabolic Health
Mold exposure and environmental toxins are far more common than most people realize. Mycotoxins are toxic compounds produced by certain molds and can enter the body through air, food, or water. Once inside, they place a significant burden on the immune system, liver, and mitochondria.
From a metabolic health perspective, mold and mycotoxins interfere with how efficiently your cells produce energy. They can trigger chronic inflammation, impair detox pathways, disrupt gut health, and affect hormone signaling. Many patients experiencing persistent fatigue, brain fog, or unexplained pain are unknowingly dealing with toxin overload that is slowing their metabolism at a cellular level.
At ViveWell Health, advanced testing allows us to identify environmental toxin exposure and understand how it is impacting your metabolic health. From there, personalized detoxification and regenerative support strategies are used to reduce toxic load and restore balance.

Metals: When Heavy Metals Weigh Down Your Metabolism
Heavy metals such as mercury, lead, arsenic, and aluminum are another major contributor to declining metabolic health. These metals accumulate over time from sources like food, water, dental materials, household products, and environmental exposure.
Metals interfere with enzyme function, mitochondrial energy production, and neurological signaling. They increase oxidative stress and inflammation, making it harder for the body to regulate blood sugar, hormones, and weight. Even low-level exposure can create significant metabolic disruption when combined with other stressors.
ViveWell Health approaches metal toxicity through precision diagnostics that assess how metals are affecting your metabolism, nervous system, and overall metabolic health. Targeted detox and regenerative therapies are then used to safely support elimination while protecting and rebuilding cellular function.
Metabolism: The Foundation of How You Feel Every Day
Metabolism is more than calories in and calories out. It is the sum of all chemical processes that allow your body to create energy, repair tissue, regulate hormones, and adapt to stress. When metabolism is compromised, every system in the body feels the impact.
Environmental toxins and metals directly impair metabolic health by damaging mitochondria, increasing inflammation, and disrupting hormone communication. Over time, this leads to symptoms like low energy, weight resistance, chronic pain, poor recovery, brain fog, and accelerated aging.
As a dedicated metabolic health clinic, ViveWell Health focuses on restoring metabolic function at its core. Through comprehensive diagnostics, lifestyle support, regenerative therapies, and personalized treatment plans, the goal is to help the body function the way it was designed to.
How ViveWell Health Addresses the 3 M’s
What sets ViveWell Health apart is an integrated approach that doesn’t chase symptoms. Instead, we address the root causes of metabolic dysfunction by targeting the 3 M’s together, not in isolation.
ViveWell Health services are designed to:
- Identify mold, mycotoxin, and metal exposure through advanced testing
- Reduce toxic burden while supporting liver and detox pathways
- Restore mitochondrial function to improve energy and resilience
- Support hormone balance, inflammation control, and metabolic efficiency
- Use regenerative and precision medicine tools to optimize healing
By improving metabolic health at the cellular level, patients often experience more consistent energy, reduced pain and inflammation, improved mental clarity, and better overall performance in daily life.
Optimizing Metabolic Health for a Better Life
True metabolic health means your body can adapt, recover, and thrive in a modern world filled with stressors. Addressing mold, metals, and metabolism together creates a powerful foundation for long-term health, not just temporary relief.
At ViveWell Health, we believe you shouldn’t have to accept chronic fatigue, pain, or feeling “off” as normal. By identifying and correcting the biggest stressors to metabolic health, our team helps patients move toward lasting vitality, resilience, and optimized wellbeing.
If you are ready to understand what’s holding your metabolism back and take a proactive approach to your health, ViveWell Health is here to guide you every step of the way.




